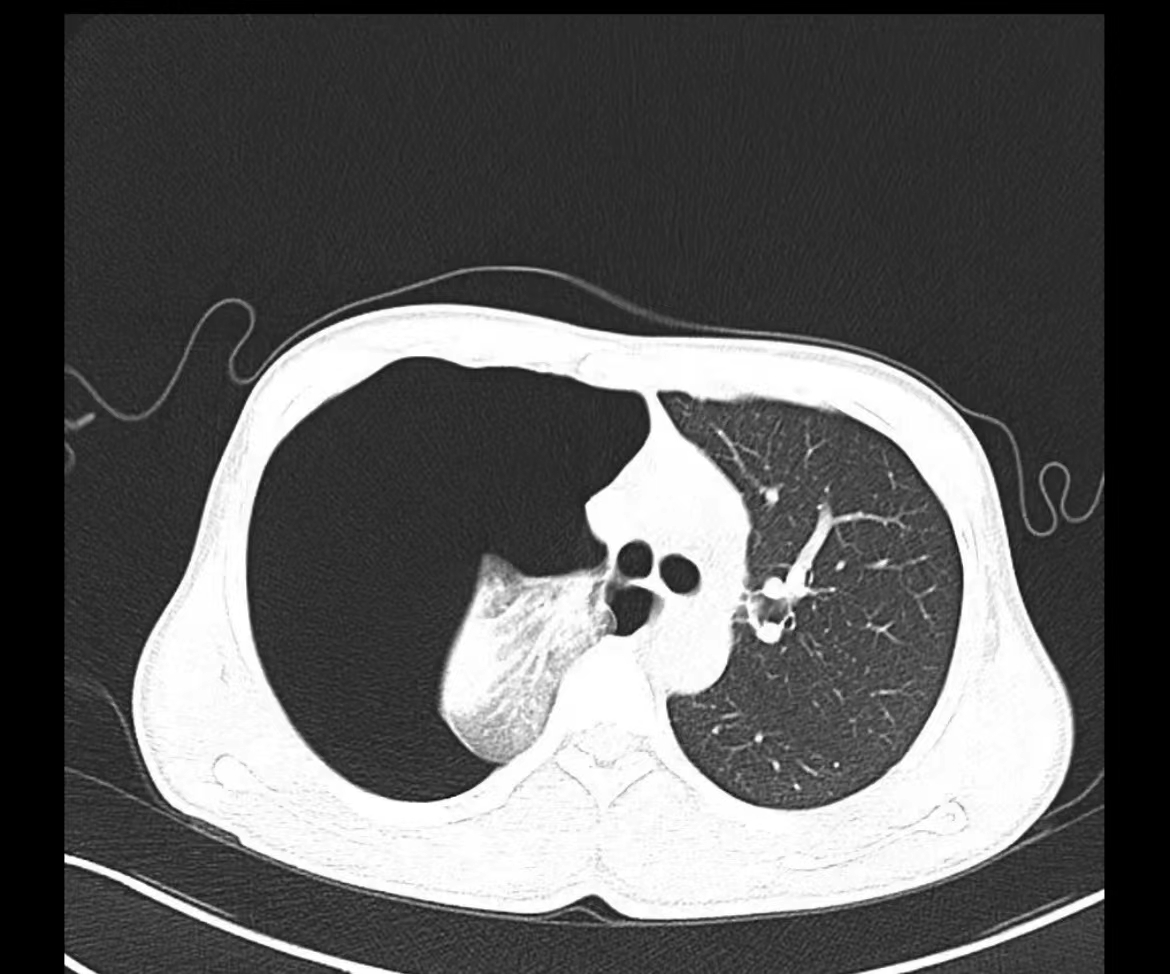
23114e4649564b8f8f3727d9b9d0e72

作者:何芳芳
夜班急诊来了一位老大娘,捂着胸口来到CT室说:“医生,快帮我检查一下吧,看我出了什么毛病,胸口痛得厉害,出气都可疼,还闷得慌!”。于是立马登记完检查信息、赶紧给她进行CT扫描,结果一看是气胸,图像如下:

老大娘下了扫描床便说:“都怪我家那儿子,30好几了还不结婚,还没说他两句还给我顶嘴,给我气得直哆嗦,然后我就开始这样了”。看来肺还真能被“气炸”了啊!
自发性气胸到底怎么回事?
正常状态下,胸膜腔是密闭的腔系,呈负压,内含有少量的液体,起到润滑胸膜的作用,减少呼吸运动时摩擦的阻力。随着呼吸进入肺内的气体,是无法进入胸膜腔的,当肺组织及脏层胸膜自发性破裂,空气便进入胸膜腔,导致胸腔中积满气体,这就是我们所说的“自发性气胸”。
自发性气胸可分为原发性气胸和继发性气胸。自发性气胸多发于瘦高体型的青壮年人群,一般男性多于女性,多见于右侧肺。因为这种身材的人胸腔较长,原发性脏肺异常发育,导致先天肺大泡或者局限的肺气肿,肺内压力骤然升高,容易导致肺大疱突然破裂,导致空气从肺部进入胸腔。继发性气胸好发于有肺部基础疾病的中老年男性,因为慢性肺气肿、肺大泡、常年气喘的情况,容易造成肺大泡破裂,形成气胸。

临床症状
一、胸痛:气胸发生时常突然出现尖锐性刺痛和刀割痛,一般是负重、剧烈咳嗽或运动后发生。
二、呼吸困难:当发生气胸时,肺部被压缩导致呼吸困难。严重程度与发作过程、肺被压缩的程度以及患者本身肺功能状态有关。年轻的呼吸功能正常的患者,可无明显的呼吸困难,即使肺被压缩>80%,也仅会在活动时稍感胸闷;而患有慢性阻塞性肺气肿的老年患者,肺被轻度压缩就有明显的呼吸困难。
三、刺激性干咳:自发性气胸时偶有无法抑制的干咳,因气体刺激胸膜所致。
影像学检查

治疗要点
保守治疗:主要适用于稳定型少量气胸,首次发生症状较轻的闭合性气胸。宜卧床休息,支气管痉挛者使用支气管扩张剂。气急、发绀者给氧,酌情给予镇静、镇痛。
排气治疗:(1)胸腔穿刺抽气 适用于小量气胸、呼吸困难较轻、心肺功能尚好的闭合性气胸病人。(2)胸腔闭式引流 适用于不稳定气胸、呼吸困难明显、肺压缩程序较重、交通性或张力性气胸、反复发生气胸的病人。
手术治疗:对于复发性气胸、长期气胸、双侧自发性气胸、血气胸等患者,可行胸腔镜下肺大疱切除术,具有切口小,术后恢复快,减少复发等优势。
如何预防
1、瘦高体型的人如果在运动中出现剧烈咳嗽,或用力过猛后突发胸痛和呼吸困难,就要警惕自发性气胸的可能,应该及时就诊,以免耽误治疗。
2、保持适量运动 虽然剧烈运动可能会导致气胸的发生,但适度的运动可以增强肺部功能和身体素质,因此适量但不过度的运动对身体是有好处的。有家族病史和患过气胸的人群需要避免剧烈运动。
3、戒烟 吸烟会导致原发性气胸的复发危险性升高,如果已经发现气胸并接受过治疗,一定要注意戒烟,同时远离二手烟。
4、避免呼吸道感染,积极治疗原发病。
5、多吃水果蔬菜,保持大便通畅,避免用力排便导致胸腹腔压力突然增高。
6、情绪上要擅于自我调节 不要过于大起大落,避免情绪的波动,生气可不是小事。